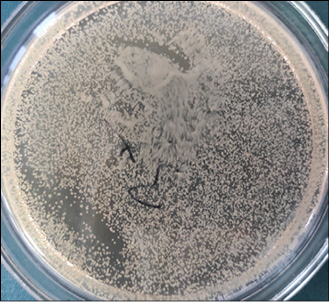

1
Сивухин А.Н. 1, Шерудилло А.С. 2
1 Федеральное государственное бюджетное образовательное учреждение высшего образования «Ивановский государственный университет»
2 Федеральное государственное бюджетное учреждение науки «Институт химии растворов имени Г.А. Крестова Российской академии наук»
Сивухин А.Н. - разработка концепции, работа с данными, анализ данных, проведение исследования, научное руководство
Шерудилло А.С. - работа с данными, анализ данных, визуализация результатов, написание черновика рукописи
Золотистый стафилококк периодически демонстрирует увеличение колониеобразующих единиц при воздействии сублетальных для него доз некоторых потенциально бактерицидных веществ, растворителей и подобных субстанций. В работе изучалось влияние диметилсульфоксида. Цель исследования – изучение влияния субингибиторных концентраций диметилсульфоксида (0,5–5 %) на морфологию кластеров, свойства клеточной стенки и количество колониеобразующих единиц Staphylococcus aureus. В работе исследовано влияние малых концентраций (0,5–5 %) диметилсульфоксида на Staphylococcus aureus. Методами световой микроскопии (окраска по Граму) и количественного посева показано, что диметилсульфоксид вызывает разделение характерных скоплений клеток на одиночные кокки и мелкие группы, что сопровождается неопределенной окраской по Граму и статистически значимым увеличением числа колониеобразующих единиц без реального прироста биомассы. Полученные данные свидетельствуют о том, что диметилсульфоксид, вероятно, воздействует на белки клеточной поверхности (в том числе белок А) и структуру пептидогликана, нарушая механизмы клеточной адгезии и деления, что приводит к артефакту завышения колониеобразующих единиц при стандартном посеве. Результаты важны для интерпретации данных микробиологических анализов при использовании диметилсульфоксида в качестве растворителя исследуемых веществ.
Staphylococcus aureus
диметилсульфоксид
белок А
кластеры
колониеобразующие единицы
клеточная стенка
биопленка
1. Tong S.Y., Davis J.S., Eichenberger E., Holland T.L., Fowler V.G. Jr. Staphylococcus aureus infections: epidemiology, pathophysiology, clinical manifestations, and management // Clin Microbiol Rev. 2015 Jul. Vol. 28 (3). P. 603–661. URL: https://pubmed.ncbi.nlm.nih.gov/26016486/ (дата обращения: 09.12.2025). DOI: 10.1128/CMR.00134-14. PMID: 26016486; PMCID: PMC4451395.
2. Бурцев М.В., Дурягина С.Н. Носительство Staphylococcus aureus (Rosenbach, 1884) среди студентов-медиков // Вестник Сыктывкарского университета. Серия 2: Естествознание. Медицина. 2019. № 11. URL: https://cyberleninka.ru/article/n/nositelstvo-staphylococcus-aureus-rosenbach-1884-sredi-studentov-medikov (дата обращения: 09.12.2025).
3. Гриценко В.А., Мавзютов А.Р., Пашкова Т.М., Карташова О.Л., Тяпаева Я.В., Белозерцева Ю.П. Генетический профиль Staphylococcus aureus, выделенных от бактерионосителей и больных с инфекционно-воспалительной патологией // Журнал микробиологии, эпидемиологии и иммунобиологии. 2018. № 4. URL: https://cyberleninka.ru/article/n/geneticheskiy-profil-staphylococcus-aureus-vydelennyh-ot-bakterionositeley-i-bolnyh-s-infektsionnovospalitelnoy-patologiey (дата обращения: 10.12.2025).
4. Абитаева Г.К., Буланин Д., Марченко Е.В., Вангелиста Л. Новые стратегии борьбы со стафилококковыми инфекциями // АМЖ. 2020. № 3. URL: https://cyberleninka.ru/article/n/novye-strategii-borby-so-stafilokokkovymi-infektsiyami (дата обращения: 08.12.2025).
5. Буйлова И.А., Савкина М.В., Саяпина Л.В., Кривых М.А., Обухов Ю.И. Оценка современного состояния фармацевтической разработки противостафилококковых профилактических препаратов // Журнал микробиологии, эпидемиологии и иммунобиологии. 2024. № 4. URL: https://cyberleninka.ru/article/n/otsenka-sovremennogo-sostoyaniya-farmatsevticheskoy-razrabotki-protivostafilokokkovyh-profilakticheskih-preparatov (дата обращения: 09.12.2025).
6. Хараева З.Ф., Эльгарова Д.А., Каблахова Н.О., Блиева Л.З., Барокова Е.Б., Камбачокова З.А., Эльмурзаева Д.А. Антибиотикочувствительность и антилизоцимная активность штаммов Staphylococcus aureus, выделенных из крови больных сепсисом // Антибиотики и химиотерапия. 2020. № 11–12. URL: https://cyberleninka.ru/article/n/antibiotikochuvstvitelnost-i-antilizotsimnaya-aktivnost-shtammov-staphylococcus-aureus-vydelennyh-iz-krovi-bolnyh-sepsisom (дата обращения: 09.12.2025).
7. Корниенко М.А., Копыльцов В.Н., Шевлягина Н.В., Диденко Л.В., Любасовская Л.А., Припутневич Т.В., Ильина Е.Н. Способность стафилококков различных видов к образованию биопленок и их воздействие на клетки человека // Молекулярная генетика, микробиология и вирусология. 2016. № 1. URL: https://cyberleninka.ru/article/n/sposobnost-stafilokokkov-razlichnyh-vidov-k-obrazovaniyu-bioplenok-i-ih-vozdeystvie-na-kletki-cheloveka (дата обращения: 09.12.2025).
8. Пруссова В.Н., Влахно С.Н. Микробиологические исследования биологического материала на выявление патогенного стафилококка на территории уссурийского городского округа // Здоровье. Медицинская экология. Наука. 2015. № 4. URL: https://cyberleninka.ru/article/n/mikrobiologicheskie-issledovaniya-biologicheskogo-materiala-na-vyyavlenie-patogennogo-stafilokokka-na-territorii-ussuriyskogo (дата обращения: 09.12.2025).
9. Усаева Я.С., Дакаева З.М., Индербаева З.И. Характеристика микроорганизмов рода Staphylococcus // Известия Чеченского государственного университета. 2022. № 1 (25). С. 30–35. URL: https://www.elibrary.ru/item.asp?id=48211396/ (дата обращения: 09.12.2025).
10. Уткина Т.М., Попова Л.П., Карташова О.Л., Хазеева Г.Д., Халиуллина А.А. Фенотипическая характеристика и генетические детерминанты патогенности Staphylococcus aureus, выделенных у бактерионосителей, проживающих на территориях с разным уровнем антропогенного загрязнения воздушной среды // Журнал микробиологии, эпидемиологии и иммунобиологии. 2015. № 4. URL: https://cyberleninka.ru/article/n/fenotipicheskaya-harakteristika-i-geneticheskie-determinanty-patogennosti-staphylococcus-aureus-vydelennyh-u-bakterionositeley (дата обращения: 10.12.2025).
11. Shettigar K., Jain S., Bhat D.V., Acharya R., Ramachandra L., Satyamoorthy K., Murali T.S. Virulence determinants in clinical Staphylococcus aureus from monomicrobial and polymicrobial infections of diabetic foot ulcers // J Med Microbiol. 2016 Dec. Vol. 65 (12). P. 1392–1404. URL: https://pubmed.ncbi.nlm.nih.gov/27902390/ (дата обращения: 09.12.2025). DOI: 10.1099/jmm.0.000370. Epub 2016 Oct 19. PMID: 27902390.
12. Гордина Е.М., Горовиц Э.С., Поспелова С.В. Факторы персистенции стафилококков, изолированных от бактерионосителей // Вестник ПГУ. Биология. 2017. № 2. URL: https://cyberleninka.ru/article/n/faktory-persistentsii-stafilokokkov-izolirovannyh-ot-bakterionositeley (дата обращения: 10.12.2025).
13. Честнова Т.В., Гладких П.Г., Короткова А.С. Эффективность диметилсульфоксида на биопленкообразование штаммами Staphylococcus aureus, как показатель восстановительных реакций при гнойно-воспалительных процессах // Вестник новых медицинских технологий. Электронное издание. 2017. № 3. URL: https://cyberleninka.ru/article/n/effektivnost-dimetilsulfoksida-na-bioplenkoobrazovanie-shtammami-staphylococcus-aureus-kak-pokazatel-vosstanovitelnyh-reaktsiy-pri (дата обращения: 09.12.2025).
14. Aguilar J., Urday-Cornejo V., Donabedian S., Perri M., Tibbetts R., Zervos M. Staphylococcus aureus meningitis: case series and literature review // Medicine (Baltimore). 2010 Mar. Vol. 89 (2). P. 117–125. URL: https://pubmed.ncbi.nlm.nih.gov/20517182/ (дата обращения: 09.12.2025). DOI: 10.1097/MD.0b013e3181d5453d. PMID: 20517182.
Введение
Золотистый стафилококк (S. aureus) является одним из наиболее клинически значимых оппортунистических патогенов, вызывающих широкий спектр инфекций – от локальных поражений кожи до жизнеугрожающих сепсиса, пневмоний и эндокардитов [1–3]. Постоянные изменения генома стафилококка вынуждают человечество искать новые способы борьбы с ним [4–6]. Одной из ключевых характеристик S. aureus, важной для его вирулентности и диагностики, является способность образовывать скопления (кластеры), напоминающие гроздья винограда. Эта особенность обусловлена неполным расхождением дочерних клеток после деления [7–9].
Классические работы показали, что за агрегацию клеток в значительной степени ответственен белок А – поверхностный белок, ковалентно связанный с пептидогликаном клеточной стенки и обладающий способностью неспецифически связывать Fc-фрагмент иммуноглобулинов G [10]. Однако современные данные указывают на комплексность этого процесса. Помимо белка А, в клеточной адгезии и формировании кластеров участвуют другие поверхностные белки (например, SasG), а также на это влияют особенности синтеза и ремоделирования пептидогликана под действием аутолизинов [11]. Нарушение работы этих систем может приводить к диссоциации кластеров на одиночные кокки, что меняет физические и биологические свойства культуры.
Диметилсульфоксид (ДМСО) – широко используемый в биологических исследованиях полярный апротонный растворитель, обладающий свойствами пенетранта, криопротектора и модулятора клеточной дифференцировки [12]. Известно, что ДМСО в высоких концентрациях (более 5 %) способен ингибировать образование биопленок у S. aureus, что связывают с его воздействием на экспрессию генов вирулентности и общие метаболические процессы [13–15]. Однако влияние низких, субингибиторных концентраций ДМСО (менее 5 %) на морфологию и культуральные свойства стафилококков изучено недостаточно. Такие концентрации часто используются в экспериментах для растворения гидрофобных соединений, при этом его собственное влияние учитывается не всегда.
Цель исследования – изучение влияния субингибиторных концентраций ДМСО (0,5–5 %) на морфологию кластеров, свойства клеточной стенки и количество КОЕ Staphylococcus aureus.
Материалы и методы исследования
Для оценки дисагрегационного эффекта субингибиторных концентраций ДМСО использовались суспензии S. aureus в физиологическом растворе. Контрольная и опытные суспензии высевались газоном на солевой агар (Стафилококкагар, ТУ 9398-109-78095326-2010). Инкубирование проводилось в суховоздушном термостате СКТБ ТС-1/20 при температуре 37 ºС в течение 48 ч. Изучение мазков производилось с помощью микроскопа «Микромед Р-1 led» с масляной иммерсией. Подсчет колоний производился с помощью стереомикроскопа МС-1 вар.2C.
Результаты исследования и их обсуждение
Исследования показали, что низкие концентрации ДМСО увеличивают число КОЕ S. aureus по сравнению с контрольными посевами (рис. 1). Это можно объяснить разрушением гроздевидных структур с распадом до более мелких групп и отдельных кокков, каждый из которых может дать собственную колонию на питательной среде. Максимальное увеличение числа КОЕ отмечено при концентрации ДМСО 3 %. Уменьшение этого значения при увеличении концентрации КОЕ до 5 % можно объяснить либо выкристаллизовыванием растворителя (рис. 2), либо началом ингибирующего его действия на клетки бактерий [12].
При микроскопировании отмечается уменьшение числа клеток в агрегатах и увеличение числа одиночных клеток в колониях, подвергнутых воздействию ДМСО. Также в них клетки хуже воспринимают окраску по Граму, демонстрируя более розовый оттенок (рис. 3, 4). Помимо этого, отмечен характерный «ползучий рост» колоний, указывающий на снижение агрегационной способности материнских клеток (рис. 5).

Рис. 1. Повышение числа КОЕ S. aureus при воздействии на исходную суспензию низких концентраций ДМСО Примечание: составлен авторами по результатам данного исследования

Рис. 2. Кристаллизация ДМСО в суспензии микроорганизмов, х1600 Примечание: составлен авторами по результатам данного исследования

Рис. 3. Мазок колонии S. aureus из контрольной серии, х1600, окраска по Граму Примечание: составлен авторами по результатам данного исследования

Рис. 4. Мазок колонии S. aureus из опытной серии при воздействии 5 % ДМСО, х1600, окраска по Граму Примечание: составлен авторами по результатам данного исследования
Рис. 5. Характерный «ползучий рост» колоний S. aureus (в центре чашки) при концентрации ДМСО в опытной суспензии 5 % Примечание: составлен авторами по результатам данного исследования
Полученные результаты демонстрируют комплексное воздействие малых концентраций ДМСО (0,5–5 %) на S. aureus. Наблюдаемое разделение кластеров согласуется с гипотезой о воздействии растворителя на поверхностные структуры клетки. ДМСО, известный своим свойством нарушать водородные связи и проникать через липидные бислои, мог:
− модифицировать белок А: изменение конформации или маскировка белка А может нарушить его роль в агрегации клеток;
− влиять на аутолизины: ДМСО может модулировать активность ферментов, ответственных за разделение дочерних клеток (например, амидазы Atl), приводя к их преждевременной или неполной активности;
− изменять свойства пептидогликана и плазматической мембраны: это объясняет неопределенный результат окраски по Граму, которая зависит от целостности и заряда клеточной стенки. Денатурирующее действие ДМСО на белки может повышать проницаемость стенки для красителей.
Данные дополняют работы прошлых лет, показывая, что даже крайне низкие концентрации ДМСО (0,5–5 %) не влияющие на образование зрелой биопленки, способны влиять на первичную адгезию и кластерообразование – ключевые начальные этапы формирования биопленки и колонии [11, 12].
Результаты подчеркивают необходимость строгого учета эффекта ДМСО в экспериментах. Его использование в качестве растворителя при скрининге антимикробных или антибиопленочных соединений против S. aureus может привести к ложноположительным результатам – синергическому эффекту за счет диссоциации кластеров исследуемым веществом и ДМСО.
Выводы
1. Субингибиторные концентрации ДМСО (0,5–5 %) вызывают диссоциацию характерных кластеров S. aureus на одиночные кокки и мелкие группы.
2. Обработка ДМСО приводит к изменению свойств клеточной стенки, что проявляется в грамвариабельной окраске, что указывает на структурные изменения пептидогликана и/или поверхностных белков.
3. Наблюдаемое значительное увеличение числа КОЕ после воздействия ДМСО является методическим артефактом, обусловленным физическим разделением уже существовавших в суспензии кластеров, а не стимуляцией размножения бактерий.
4. Феномен «ползучего роста» на газонных посевах подтверждает гипотезу о снижении адгезивной способности клеток под действием ДМСО.
5. Полученные данные необходимо учитывать при планировании экспериментов с использованием ДМСО в качестве растворителя для изучения свойств S. aureus, особенно при подсчете КОЕ и оценке антибиопленочной активности.
Конфликт интересов
Авторы заявляют об отсутствии конфликта интересов
Библиографическая ссылка
Сивухин А.Н., Шерудилло А.С. ВЛИЯНИЕ СУБИНГИБИТОРНЫХ КОНЦЕНТРАЦИЙ ДИМЕТИЛСУЛЬФОКСИДА НА ДИССОЦИАЦИЮ КЛАСТЕРОВ, МОРФОЛОГИЮ КЛЕТОЧНОЙ СТЕНКИ И КОЛИЧЕСТВО КОЛОНИЕОБРАЗУЮЩИХ ЕДИНИЦ STAPHYLOCOCCUS AUREUS // Международный журнал прикладных и фундаментальных исследований. 2025. № 12.
С. 5-8;
URL: https://applied-research.ru/ru/article/view?id=13773 (дата обращения: 01.07.2026).
DOI: https://doi.org/10.17513/mjpfi.13773